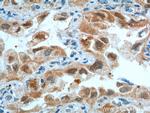
CDK4 Antibody in Immunohistochemistry (Paraffin) (IHC (P))
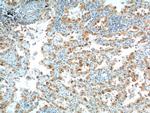
CDK4 Antibody in Immunohistochemistry (Paraffin) (IHC (P))

Search
Proteintech
CDK4 Polyclonal Antibody
{{$productOrderCtrl.translations['antibody.pdp.commerceCard.promotion.promotions']}}
{{$productOrderCtrl.translations['antibody.pdp.commerceCard.promotion.viewpromo']}}
{{$productOrderCtrl.translations['antibody.pdp.commerceCard.promotion.promocode']}}: {{promo.promoCode}} {{promo.promoTitle}} {{promo.promoDescription}}. {{$productOrderCtrl.translations['antibody.pdp.commerceCard.promotion.learnmore']}}
产品信息
11026-1-AP
种属反应
已发表种属
宿主/亚型
分类
类型
抗原
偶联物
形式
浓度
规格
纯化类型
保存液
内含物
保存条件
运输条件
产品详细信息
Immunogen sequence: MATSRYEPV AEIGVGAYGT VYKARDPHSG HFVALKSVRV PNGGGGGGGL PISTVREVAL LRRLEAFEHP NVVRLMDVCA TSRTDREIKV TLVFEHVDQD LRTYLDKAPP PGLPAETIKD LMRQFLRGLD FLHANCIVHR DLKPENILVT SGGTVKLADF GLARIYSYQM ALTPVVVTLW YRAPEVLLQS TYATPVDMWS VGCIFAEMFR RKPLFCGNSE ADQLGKIFDL IGLPPEDDWP RDVSLPRGAF PPRGPRPVQS VVPEMEESGA QLLLEMLTFN PHKRISAFRA LQHSYLHKDE GNPE (1-303 aa encoded by BC010153)
靶标信息
CDK4/cyclin D3 serine/threonine kinase is dimeric protein complex. CDK4 is a member of the cyclin-dependent protein kinase family and is involved in the control of cell proliferation during the G1 phase of cell cycle. CDK4 forms a complex with the D-type cyclins and is inhibited by p16 (cyclin-dependent kinase inhibitor-2). CDK4 can mediate phosphorylation of the C-terminal region of Rb protein leading to an active transcriptional repression of E2F complex. CDC37 and HSP90 can preferentially associate with the fraction of CDK4 not bound to D-type cyclins. SMAD3 is a major physiologic substrate of the G1 cyclin-dependent kinases CDK4 and CDK2. Although CDK6 and CDK4 can both phosphorylate multiple residues in the Rb protein, they do so with different residue selectivity in vitro; CDK6 phosphorylates Thr821 while CDK4 phosphorylates Thr826 on Rb protein.
仅用于科研。不用于诊断过程。未经明确授权不得转售。
生物信息学
蛋白别名:
CDK4; Cell division protein kinase 4; CRK3; cyclin dependent kinase 4; Cyclin-dependent kinase 4; MGC14458; orf; p34
基因别名: CDK4; CMM3; Crk3; PSK-J3
UniProt ID: (Human) P11802, (Rat) P35426, (Mouse) P30285
Entrez Gene ID: (Human) 1019, (Rat) 94201, (Mouse) 12567